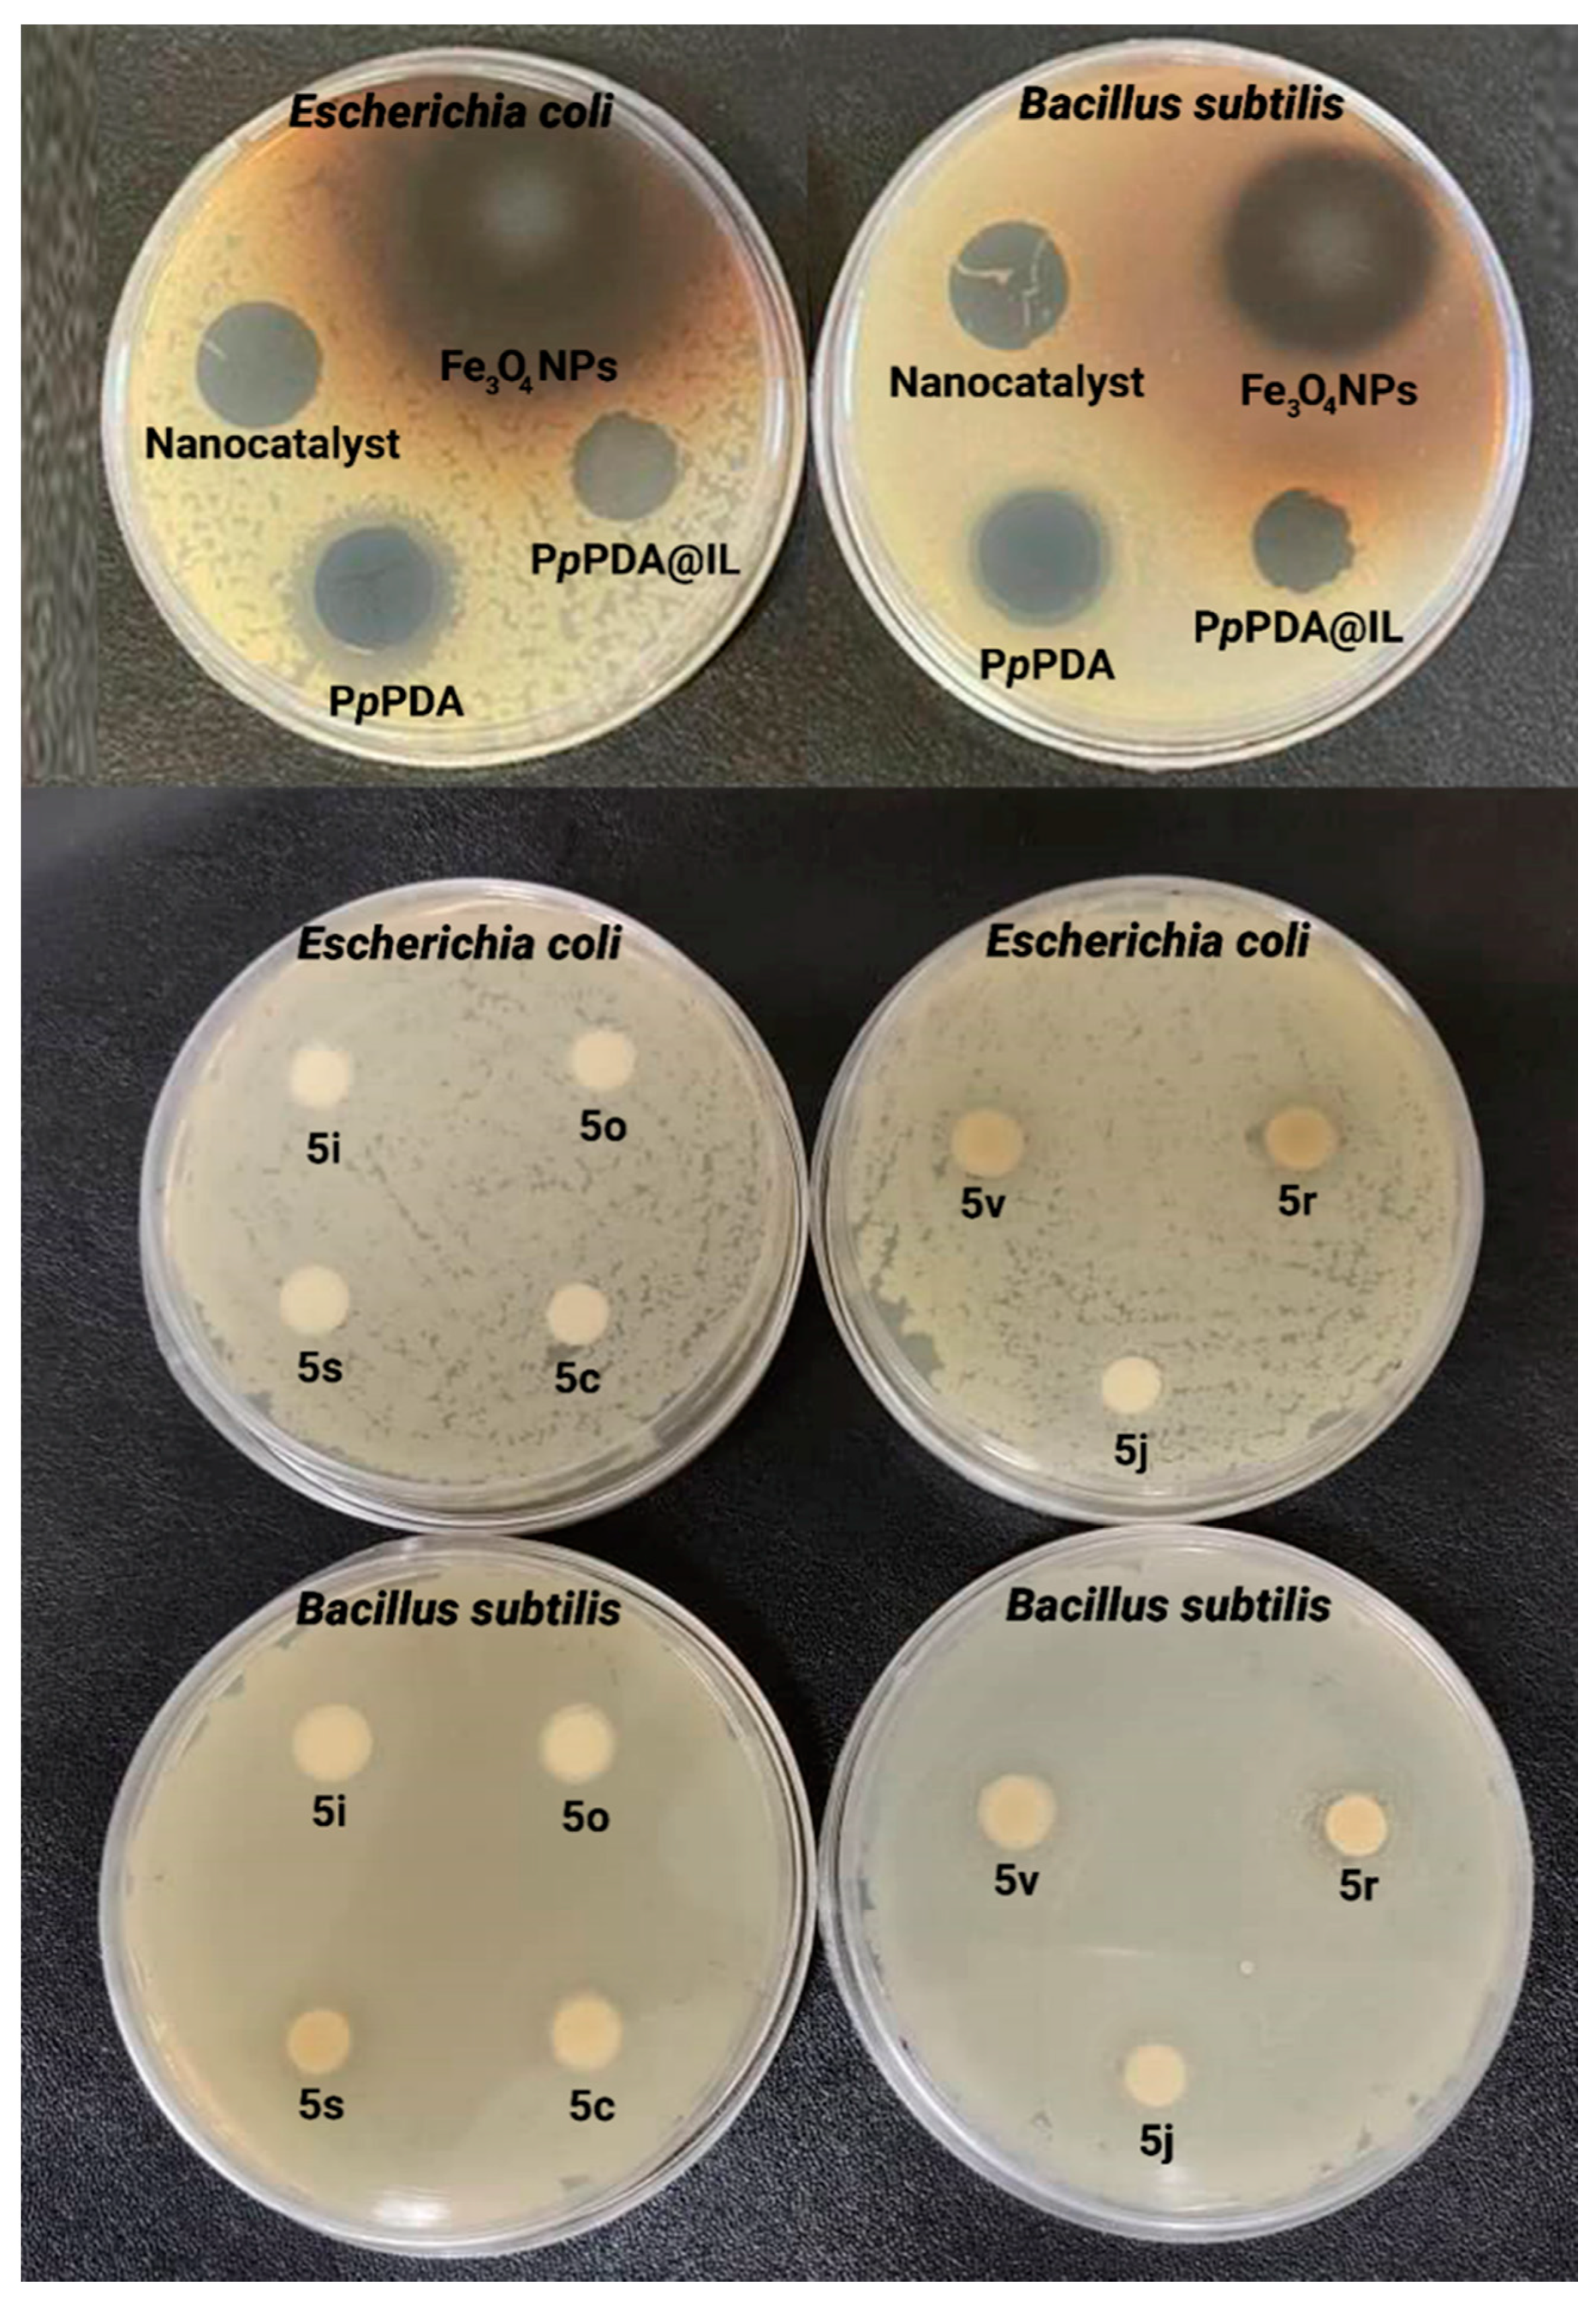
Molecules 27 01748 g006

Abstract
Antibacterial materials have obtained much attention in recent years due to the presence of hazardous agents causing oxidative stress and observation of pathogens. However, materials with antioxidant and antibacterial activities can cause toxicity due to their low biocompatibility and safety profile, urging scientists to follow new ways in the synthesis of such materials. Ionic liquids have been employed as a green and environmentally solvent for the fabrication of electrically conductive polymers. In the present study, an antibacterial poly(p-phenylenediamine)@Fe3O4 (PpPDA@Fe3O4) nanocomposite was fabricated using [HPy][HSO4] ionic liquid. The chemical preparation of PpPDA@Fe3O4 nanocomposite was initiated through the oxidative polymerization of p-phenylenediamine by ammonium persulfate in the presence of [HPy][HSO4]. The PpPDA@Fe3O4 nanocomposite exhibited antibacterial properties against Gram-negative (Escherichia coli) and Gram-positive (Bacillus subtilis) bacteria. The PpPDA@Fe3O4 nanocomposite was employed as a heterogeneous nanocatalysis for one-pot synthesis of polyhydroquinoline derivatives using aromatic aldehyde, dimedone, benzyl acetoacetate, and ammonium acetate. Polyhydroquinoline derivatives were synthesized in significant yields (90–97%) without a difficult work-up procedure in short reaction times. Additionally, PpPDA@Fe3O4 nanocatalyst was recycled for at least five consecutive catalytic runs with a minor decrease in the catalytic activity. In this case, 11 derivatives of polyhydroquinoline showed in vitro antioxidant activity between 70–98%.
1. Introduction
The ionic liquids (ILs) are considered substances with a melting point below 100 °C composed of a cation and an anion [1]. The ions present in ILs are tunable and it is possible to develop solvents and catalysts from ILs. The early reports of using ILs in enzymatic reactions were performed in 2000 [2,3]. In addition to chemical synthesis and catalysis, ILs have been employed in electrochemistry, biotechnology, and pharmaceutics [4]. The ILs have been utilized as stabilizers for DNA storage [5]. ILs have been employed in chemical investigations owing to their nonvolatility, high thermal and electrochemical stability [6]. They are environmentally friendly salts that have been employed in the synthesis of organic compounds, catalytic reactions as well as the synthesis of intrinsically conductive polymers (ICPs) [7,8].
Intrinsically conductive polymers (ICPs) such as polyaniline, polypyrrole, and polythiophene, owning to their electrical conductivity, biocompatibility, and environmental stability, have been widely applied in different arenas, e.g., water treatment, catalysts, and biomedical applications [9,10]. Among ICPs, the polyaniline derivatives such as poly(phenylenediamines) (ortho, meta, and para) have attracted special attention. Poly(phenylenediamines) are highly aromatic ladder polymers that exhibited good solubility and poor electrical conductivity compared to polyaniline [11,12,13]. They have been widely used in water treatment, biosensors, and biomedical applications [14]. In order to improve electrical conductivity, thermal stability, and viscosity of poly(phenylenediamines), ILs can be utilized [15]. Recently, ILs such as 1-alkyl-3-methylimidazolium, 1-butyl-4-methylpyridinium, quaternary ethyltributylammonium, pyridinium carboxylic acid sulfate have been employed for the synthesis of polyaniline and its derivatives [8,11,16,17]. It was reported that ILs played the role of lubricants, plasticizers, interfacial agents in polymer systems, generating enhancements in the mechanical properties, solubility, electrical conductivity, crystallinity, and thermal stability [15].
Iron oxide is an FDA-approved agent significantly applied in nanomedicine [5]. The iron oxide nanomaterials have a diameter of 15–100 nm composed of magnetite or maghemite and have shown great biomedical applications as contrast materials, drug carriers, and thermal-based therapeutics [18]. Iron oxide nanoparticles are under attention because of their excellent properties in polymer-based catalysts [19,20]. This is because iron oxide nanoparticles possess a large surface area for substrate molecules. Furthermore, after the completion of the reactions, the magnetic catalysts can be separated easily from the solution using an external magnet. Additionally, magnetic catalysts can be reused up to numerous runs almost without loss of catalytic activity [21,22].
Several papers have reported the use of PpPDA composites as an effective catalyst in organic reactions. For example, Cu2O-Cu(OH)2/PpPDA nanocomposite was used as a high-efficiency catalyst for methanol electrooxidation [23]. PpPDA/carbon black composite was employed for oxygen reduction [24]. ZnCr-layered double hydroxides/PpPDA/Cu(II) as a catalyst for the synthesis of pyrrole derivatives [25]. In another work, layered double hydroxides/PpPDA was applied as an effective catalyst for the synthesis of indolizines [26].
Hantzsch products (e.g., 1,4-dihydropyridine, polyhydroquinoline, and acridine) are products with significant biological activities. They have pharmacological properties, e.g., vasodilator, antihypertensive, bronchodilator, anti-atherosclerotic, hepatoprotective, anti-tumor, anti-mutagenic, neuroprotective, and anti-diabetic [27]. 4-Substituted 1,4-dihydropyridines (1,4-DHPs) establishes a significant class of Ca2+ channel blockers [28] and has been used as one of the most important classes of drugs for cardiovascular disease treatment [29]. Polyhydroquinolines have been prepared through conventional heating, microwave irradiation [30], and ultrasound [31].
Herein, we designed a unique organic-inorganic antibacterial and antioxidant nanocatalyst based on PpPDA and iron oxide nanoparticles with assisted [HPy][HSO4] using ammonium persulfate as an oxidant. The prepared PpPDA@Fe3O4 bioactive nanocomposite was employed as an efficient retrievable eco-friendly catalyst for the synthesis of polyhydroquinoline derivatives through the one-pot four-component reaction of dimedone, benzyl acetoacetate, ammonium acetate, and different aromatic aldehydes under mild reaction conditions (Scheme 1).
Scheme 1.
Schematic illustration of the antibacterial and antioxidant nanocatalyst for synthesis of bioactive polyhydroquinoline derivatives.
2. Results
2.1. Characterization of Polymer-Based Catalyst
FTIR: The FTIR spectra of the prepared PpPDA and PpPDA@Fe3O4 nanocomposite in the presence of the [HPy][HSO4] ionic liquid are shown in Figure 1a. The PpPDA and PpPDA@Fe3O4 nanocomposite showed very similar spectra with tiny differences. In the FTIR spectrum of PpPDA, the absorption peak at 3200–3450 cm−1 is related to the stretching vibration of the NH2 and N-H groups. Two characteristic absorption peaks at 1570 cm−1 and 1503 cm−1 are associated with the stretching mode of quinoid imine and benzenoid amine units, respectively [32]. The absorption peaks with different intensities in the areas of 1310 cm−1, 1108–1118 cm−1, and 830 cm−1 are related to the stretching vibrations of SO4, S=O, and S-OH in the [HPy][HSO4] ionic liquid, respectively [11]. The incorporation of iron oxide nanoparticles in the PpPDA matrix led to the appearance of an obvious absorption peak at around 505 cm−1 that related to the Fe-O-Fe stretching modes in Fe3O4 [33].
Figure 1.
FTIR spectra (a), EDX spectra, and tabulated data (b) and XRD patterns (c) of the prepared PpPDA and PpPDA@Fe3O4 nanocomposite in the presence of the [HPy][HSO4] ionic liquid.
Elemental analysis: Elemental analysis (CHNSO) was employed for characterization of the prepared PpPDA and PpPDA@Fe3O4 nanocomposite in the presence of the [HPy][HSO4] ionic liquid (Table 1). According to the data in Table 1, the existence of sulfur and oxygen elements in the PpPDA approved the presence of [HPy][HSO4] ionic liquid in the structure of the PpPDA. The increase of oxygen element in the PpPDA@Fe3O4 nanocomposite compared with PpPDA shows the presence of Fe3O4 nanoparticles in the nanocomposite [11].
Table 1.
Elemental analysis data of the prepared PpPDA and PpPDA@Fe3O4 nanocomposite in the presence of the [HPy][HSO4] ionic liquid. Found (Expected).
EDX: The chemical composition of the prepared PpPDA and PpPDA@Fe3O4 nanocomposite in the presence of the [HPy][HSO4] ionic liquid was also estimated using the EDX technique as revealed in Figure 1b. The comparison of spectra and tabulated data indicated the existence of different amounts of O, C, N, and S elements. The presence of S in both PpPDA and PpPDA@Fe3O4 nanocomposite is related to [HPy][HSO4] ionic liquid. In addition, the existence of Fe in the PpPDA@Fe3O4 sample indicates the iron oxide in the composite [34].
X-ray diffraction: XRD patterns of the prepared PpPDA and PpPDA@Fe3O4 nanocomposite in the presence of the [HPy][HSO4] ionic liquid are shown in Figure 1c. According to the literature, the XRD pattern of Fe3O4 nanoparticles indicated a crystalline nature [35]. A semicrystalline nature was observed in the XRD pattern of PpPDA owing to intermolecular interactions between the PpPDA chains and the [HPy][HSO4] ionic liquid [36]. The XRD pattern of PpPDA@Fe3O4 nanocomposite showed more crystallinity compared with PpPDA due to the presence of crystalline nanoparticles of Fe3O4 [37].
FESEM: The morphology of Fe3O4 nanoparticles, PpPDA, and PpPDA@Fe3O4 nanocomposite was investigated using FESEM. The FESEM micrographs of the prepared Fe3O4 nanoparticles (a), PpPDA (b), and PpPDA@Fe3O4 nanocomposite (c) are shown in Figure 2. The FESEM micrograph of Fe3O4 nanoparticles shows a spherelike structure with a diameter of ~50 nm. Polyhedral shapes with diameters of ~150 nm and ~100 nm observe in the FESEM micrographs of PpPDA, and PpPDA@Fe3O4 nanocomposite, respectively.
Figure 2.
FESEM micrographs of Fe3O4 nanoparticles (a), PpPDA (b), and PpPDA@Fe3O4 nanocomposite (c) in the presence of the [HPy][HSO4] ionic liquid. VSM curve (d) of the prepared PpPDA@Fe3O4 nanocomposite in the presence of the [HPy][HSO4] ionic liquid.
VSM: Vibrating sample magnetometer (VSM) was employed for the evaluation of the magnetic property of PpPDA@Fe3O4 nanocomposite as shown in Figure 2d. In the VSM of the PpPDA@Fe3O4 nanocomposite, the amount of magnetic coercivity (Hc) and magnetic remanence (Mr) is equal to zero. This indicates the PpPDA@Fe3O4 nanocomposite has a superparamagnetic property with a magnetization saturation value of 30.01 emu/g [38].
Solubility test: The solubility of the prepared PpPDA in the presence and absence of [HPy][HSO4], as well as the PpPDA@Fe3O4 magnetic nanocomposite prepared in [HPy][HSO4] in different solvents, were studied (Table 2). The results indicate that the presence of [HPy][HSO4] improves the solubility of the PpPDA. On the other hand, the presence of Fe3O4 nanoparticles in PpPDA leads to reducing in the solubility of the PpPDA.
Table 2.
Solubility behavior of the PpPDA and PpPDA@Fe3O4.
2.2. Evaluation of the Catalytic Activity of PpPDA@Fe3O4 Nanocomposite
In the current study, we offered a new and efficient technique for the synthesis of polyhydroquinolines using PpPDA@Fe3O4 nanocomposite. We investigated the four-component Hantzsch condensation by aromatic aldehyde, dimedone, benzyl acetoacetate, and ammonium acetate.
The effect of various solvents on the reaction rate and yield of the products was investigated to optimize the reaction conditions.
To optimize the reaction conditions, firstly the various solvents’ effect on the rate of reaction and products yield was investigated. The reaction of benzaldehyde (1, 1 mmol), dimedon, (2, 1 mmol), ammonium acetate (3, 1 mmol), and benzyl acetoacetate (4, 1 mmol) as a model reaction was catalyzed by 0.03 g of PpPDA@Fe3O4 in different solvents, e.g., water, ethanol (EtOH), chloroform (CHCl3), tetrahydrofuran (THF) and hexane at reflux conditions (Table 3). In aprotic solvents, e.g., CHCl3, THF, and hexane, the reaction rate was very slow and product yield was low whereas reaction rates, as well as product yields in protic solvents, were improved. In water and solvent-free conditions, the expected product was achieved only in low yield after 4 h. Furthermore, the above condensation reaction by the PpPDA@Fe3O4 catalyst was also carried out in ethanol at reflux conditions.
Table 3.
Optimization of the four-component reaction of dimedone, benzaldehyde, benzyl acetoacetate, and ammonium acetate under various conditions a.

To optimize the temperature of the reaction, the mixture was heated at various temperatures. The yield of the products was increased when the reaction temperature was raised from room temperature to reflux conditions. Moreover, when 0.02, 0.03, 0.04, and 0.06 of PpPDA@Fe3O4 nanocatalyst were used, the yield of the products was 60%, 85%, 94%, and 96%, respectively. Therefore, 0.04 g of PpPDA@Fe3O4 was an optimal amount for producing products with high yields. For better comparison, the reaction was also investigated in the absence of the catalyst. Results (Table 3) showed that the rate of reaction was very slow and product yield was low.
For better comparison, the synthesis of polyhydroquinoline derivatives was studied in the absence and presence of various catalysts, e.g., PpPDA, PpPDA@[HPy][HSO4], PpPDA@Fe3O4@[HPy][HSO4] under the same conditions, and the results are shown in Table 4. The results display that the PpPDA@[HPy][HSO4] has better catalytic properties than the PpPDA. The major problem of PpPDA catalyst is easy solubility in organic solvents and therefore its isolation is difficult. In addition, results showed that the use of 60 mg of PpPDA@Fe3O4@[HPy][HSO4] catalyst under the same reaction conditions reduce the reaction time and increased the reaction yield. Consequently, the PpPDA@Fe3O4@[HPy][HSO4] nanocatalyst was selected as an effective catalyst to perform the reactions.
Table 4.
Influence of the catalyst in the synthesis of polyhydroquinoline derivatives under various conditions a.
Table 5 shows that aromatic aldehydes containing electron-donating and electron-withdrawing groups reacted with dimedone, benzyl acetoacetate, and ammonium acetate in the presence of PpPDA@Fe3O4 magnetic nanocatalyst in optimal conditions and in a short time to produced polyhydroquinolines with excellent yields. Likewise, thiophene-carbaldehyde and furfural (heteroaromatic aldehydes) produced the desired product after 35 min with 92% and 90% yields respectively (Table 5, entries 12 and 14). PpPDA@Fe3O4 magnetic nanocatalyst was also suitable for the synthesis of polyhydroquinolines from aliphatic aldehyde such as α-methyl cinnamaldehyde (Table 5, entry 13). Dialdehydes such as para phenylene dialdehyde and 2,2′-(hexane-1,6-diylbis(oxy))dibenzaldehyde reacted under optimal conditions using PpPDA@Fe3O4 magnetic nanocatalyst and produced products with high yields (Table 5, entries 23 and 24).
Table 5.
Conversion of benzaldehyde derivatives to polyhydroquinolines in the presence of PpPDA@Fe3O4 magnetic nanocatalyst a.

Proposed mechanistic scheme: The PpPDA@Fe3O4 nanocomposite with active sites such as base (secondary amines in polymer backbone), Brønsted acid ([HPy][HSO4], Lewis acid site (Fe3+ in Fe3O4), and large surface area, play a significant role in all steps of reactions as demonstrated in Figure 3. First, dimedone is activated in the presence of amine groups in PpPDA, and then, as a nucleophile, attacks the aldehyde activated by the [HPy][HSO4] to form intermediate (I) (Knoevenagel condensation). On the other hand, ammonium acetate is converted to acetic acid and ammonia, and then the ammonia as a nucleophile attacks the benzyl acetate activated by the [HPy][HSO4] to form intermediate (II). In the next step, Michael’s addition reaction of intermediate (II) to intermediate (I) causes the formation of intermediate (III). The intermediate (III) is then converted to the intermediate (IV) by tautomerization and the product (VI) is obtained after cyclization reaction.
Figure 3.
Proposed mechanistic scheme for the synthesis of polyhydroquinolines derivatives catalyzed by PpPDA@Fe3O4 nanocomposite. Note: The relative size of nanoparticles and chemical structures in the scheme is assumptive.
Recovery and reusability: Recyclability is an important property of heterogeneous catalytic systems in terms of environmental protection and industrial application. To evaluate the reusability of PpPDA@Fe3O4, it was magnetically isolated from the reaction mixture, washed several times with distilled water and ethanol, dried at room temperature, utilized again in the next reaction. As is observed in Figure 4, the yield of the products was not reduced considerably after five successive catalytic runs and the catalyst has retained its efficacy and stability in the synthesis of polyhydroquinolines derivatives.
Figure 4.
The Reusability of PpPDA@Fe3O4 in the synthesis of polyhydroquinoline derivatives.
Antioxidant activity: The antioxidant activity of Fe3O4 NPs, PpPDA, PpPDA@[HPy][HSO4], PpPDA@Fe3O4@[HPy][HSO4], and synthesized polyhydroquinoline derivatives was studied using the 2,2-diphenyl-1-picrylhydrazyl (DPPH)radical scavenging model (Figure 5). Results showed that all used materials to prepare magnetic nanocatalysts had antioxidant activities between 72% and 90%. In addition, the antioxidant activity of 24 synthesized derivatives was investigated. Only 11 derivatives showed antioxidant activity between 75% and 98%. These results suggest that these derivatives may play a role in the synthesis of immune-boosting drugs.
Figure 5.
The histograms (a,b) and the photographs (c–e) of antioxidant activity of Fe3O4 NPs, PpPDA, PpPDA@[HPy][HSO4], PpPDA@Fe3O4@[HPy][HSO4], and synthesized polyhydroquinoline derivatives.
Antibacterial activity: The in vitro antibacterial activities of the Fe3O4 NPs, PpPDA, PpPDA@[HPy][HSO4] (PpPDA@IL), PpPDA@Fe3O4@[HPy][HSO4] (nanocatalyst), and seven of polyhydroquinoline derivatives (5c, 5i, 5j, 5r, 5s, 5o, and 5v) were investigated against Escherichia coli and Bacillus subtilis, and results shown in Table 6 and Figure 6. The results showed that the bare PpPDA and Fe3O4 NPs had good growth inhibitory effects against tested microorganisms, and among them, Fe3O4 NPs exhibited the highest antibacterial activity against both microorganisms while PpPDA@IL was effective against Bacillus subtilis. The nanocatalyst showed lower antimicrobial activity than that of bare minerals against tested bacteria. Moreover, among polyhydroquinoline derivatives, only 5r and 5v had good growth inhibitory effects against tested microorganisms while 5i and 5o showed no effect against tested microorganisms.
Table 6.
Antibacterial activities data of catalysts and some polyhydroquinoline derivatives via Kirby–Bauer disc diffusion technique.
Figure 6.
Antibacterial activities of catalysts and some polyhydroquinoline derivatives against Escherichia coli and Bacillus subtilis via Kirby–Bauer disc diffusion technique.
Spectroscopic Data (1H-NMR and 13C-NMR of products are shown in Supplementary Materials)
Benzyl2,7,7-trimethyl-4-(4-nitrophenyl)-5-oxo-1,4,5,6,7,8-hexahydroquinoline-3-carboxylate (Table 5, Entry 2, Figures S1 and S2)
Solid, m.p.148–150 °C. 1H NMR (400 MHz, DMSO-d6): δ (ppm) 0.80 (s, 3H, CH3), 1.00 (s, 3H, CH3), 1.97 (d, 1H, J = 16 Hz, CH2), 2.18 (d, 1H, J = 16 Hz, CH2), 2.32 (s, 3H, CH3), 2.27–2.246 (m, 2H, CH2), 4.96–5.61 (m, 1H, benzilic, OCH2 benzilic), 7.16–7.37 (m, 7H, aromatic), 8.04 (d, 2H, J = 8 Hz), 9.33 (s, 1H, NH), 13C-NMR (100 MHz, DMSO-d6): δ (ppm) 18.93, 26.87, 29.46, 32.62, 37.06, 40.58, 45.41, 50.50, 65.38, 102.34, 109.59, 123.63, 128.29, 128.73, 129.25, 136.93, 146.07, 147.44, 150.47, 155.27, 166.61, 194.77.
Benzyl4-(3-ethoxy-4-hydroxyphenyl)-2,7,7-trimethyl-5-oxo-1,4,5,6,7,8-hexahydroquinoline-3-carboxylate (Table 5, Entry 3, Figures S3 and S4)
Solid, m.p.209–211 °C. 1H NMR (400 MHz, DMSO-d6): δ (ppm) 0.85(s, 3H, CH3), 1.00 (s, 3H, CH3), 1.24 (t, 3H, J = 6.8 Hz CH3), 1.97 (d, 1H, J = 16.4 Hz, CH2), 2.13 (d, 1H, J = 16.4 Hz, CH2), 2.29 (s, 3H, CH3), 2.24–2.29 (m, 2H, CH2), 2.41(d, 2H, J = 17.2 Hz, CH2), 4.77 (s, 1H, benzilic), 5.33 (AB q, 2H, J = 12 Hz, OCH2 benzilic), 6.46–6.63 (m, 3H, aromatic), 7.22–7.33 (m, 5H, aromatic), 8.56 (s, 1H, OH) 9.07 (s, 1H, NH), 13C-NMR (100 MHz, DMSO-d6): δ (ppm) 15.23, 18.58, 26.82, 29.67, 32.60, 35.41, 50.76, 64.06, 65.22, 103.90, 110.92, 113.96, 115.49, 120.06, 128.11, 128.16, 128.75, 137.19, 139.30, 145.29, 145.84, 146.23, 149.52, 167.28, 194.88.
Benzyl2,7,7-trimethyl-5-oxo-4-(3,4,5-trimethoxyphenyl)-1,4,5,6,7,8-hexahydroquinoline-3-carboxylate (Table 5, Entry 5, Figures S5 and S6)
Solid, m.p.140–142 °C. 1H NMR (400 MHz, DMSO-d6): δ (ppm) 0.91 (s, 3H, CH3), 1.02 (s, 3H, CH3), 2.02 (d, 1H, J = 16 Hz, CH2), 2.19 (d, 1H, J = 15.6 Hz, CH2), 2.31 (s, 3H, CH3), 2.31–2.47 (m, 2H, CH2), 3.37 (s, 6H, OCH3), 3.55 (s, 3H, OCH3), 4.86 (s, 1H, benzilic), 5.08 (AB q, 2H, J = 12 Hz, OCH2 benzilic), 6.37 (s, 2H, aromatic), 7.25–7.33 (m, 5H, aromatic), 9.17 (s, 1H, NH). 13C-NMR (100 MHz, DMSO-d6): δ (ppm) 18.90, 19.03, 21.51, 26.75, 29.70, 31.62, 32.61, 36.20, 50.70, 55.98, 60.33, 65.29, 66.07, 103.57, 105.05, 110.37, 126.87, 127.61, 127.85, 128.22, 128.79, 136.13, 137.21, 143.75, 146.30, 150.13, 167.19, 172.53, 194.96.
Benzyl2,7,7-trimethyl-5-oxo-4-(p-tolyl)-1,4,5,6,7,8-hexahydroquinoline-3-carboxylate (Table 5, Entry 9, Figures S7 and S8)
Solid, m.p.165–167 °C. 1H-NMR (400 MHz, DMSO-d6): δ (ppm) 0.83 (s, 3H, CH3), 1.00 (s, 3H, CH3), 1.96 (d, 1H, J = 16 Hz, CH2), 2.13 (d, 1H, J = 16 Hz, CH2), 2.20 (s, 3H, CH3), 2.25 (s, 3H, CH3), 2.25–2.39 (m, 2H, CH2), 2.41(d, 2H, J = 30 Hz, CH2), 4.84 (s, 1H, benzilic), 5.01 (AB q, 2H, J = 12.8 Hz, OCH2 benzilic), 6.96 (d, 2H, J = 8 Hz, aromatic), 7.01 (d, 2H, J = 8 Hz, aromatic), 7.19–7.32 (m, 5H, aromatic), 9.12 (s, 1H, NH), 13C-NMR (100 MHz, DMSO-d6): δ (ppm) 18.87, 21.07, 21.78, 26.90, 29.61, 32.60, 35.20, 39.32, 46.93, 50.70, 65.22, 103.68, 110.72, 128.18, 128,74, 135.07, 137.14, 145.11, 146.12, 149.70, 167.12, 172.73, 194.77.
Benzyl2,7,7-trimethyl-5-oxo-4-(p-tolyl)-1,4,5,6,7,8-hexahydroquinoline-3-carboxylate (Table 5, Entry 10, Figures S9 and S10)
Solid, m.p.126–128 °C. 1H NMR (400 MHz, DMSO-d6): δ (ppm) 0.83 (s, 3H, CH3), 1.00 (s, 3H, CH3), 1.97 (d, 1H, J = 15.6 Hz, CH2), 3.94 (d, 1H, J = 16.4 Hz, CH2), 2.30 (s, 3H, CH3), 2.41 (s, 3H, SCH3), 2.25–2.42 (m, 2H, CH2), 2.53 (d, 2H, J = 20 Hz, CH2), 4.83 (s, 1H, benzilic), 5.02 (AB q, 2H, J = 12 Hz, OCH2 benzilic), 7.06–7.30 (m, 9H, aromatic), 9.15 (s, 1H, NH), 13C-NMR (100 MHz, DMSO-d6): δ (ppm) 15.31, 18.88, 26.95, 29.57, 32.62, 35.85, 50.67, 65.23, 103.41, 110.47, 125.62, 126.08, 128.18, 128.64, 128.75, 135.30, 137.12, 144.90, 146.320, 146.80, 167.02, 194.79.
Benzyl4-(4-ethylphenyl)-2,7,7-trimethyl-5-oxo-1,4,5,6,7,8-hexahydroquinoline-3-carboxylate (Table 5, Entry 13, Figures S11 and S12)
Solid, m.p.165–167 °C. 1H NMR (400 MHz, DMSO-d6): δ (ppm) 0.84 (s, 3H, CH3), 1.00 (s, 3H, CH3), 1.13 (t, 3H, J = 8 Hz, CH3), 1.97 (d, 1H, J = 15.6 Hz, CH2), 2.15 (d, 1H, J = 16.4 Hz, CH2), 2.29 (s, 3H, CH3), 2.26–2.48 (m, 2H, CH2), 4.84 (s, 1H, benzilic), 5.02 (AB q, 2H, J = 12 Hz, OCH2 benzilic), 7.01 (dd, 4H, J = 8, 15.6 aromatic),7.18–7.41 (m, 4H, aromatic) 9.11 (s, 1H, NH), 13C-NMR (100 MHz, DMSO-d6): δ (ppm) 16.09, 18.90, 27.01, 28.23, 29.57, 32.62, 35.81, 50.72, 65.21, 103.74, 110.71, 127.60, 127.94, 128.16, 128.72, 137.17, 141.43, 145.38, 146.11, 149.75, 167.13, 194.77.
Benzyl4-(3,4-dimethoxyphenyl)-2,7,7-trimethyl-5-oxo-1,4,5,6,7,8-hexahydroquinoline-3-carboxylate (Table 5, Entry15, Figure S13)
Solid, m.p.151–153–167 °C. 1H NMR (400 MHz, DMSO-d6): δ (ppm) 0.86 (s, 3H, CH3), 1.01 (s, 3H, CH3), 1.99 (d, 1H, J = 16 Hz, CH2), 2.17 (d, 1H, J = 16.4 Hz, CH2), 2.31 (s, 3H, CH3), 2.19–2.50 (m, 2H, CH2), 247 (d, 2H, J = 24 Hz, CH2), 3.53 (s, 3H, OCH3), 3.67 (s, 3H, OCH3), 4.84 (s, 1H, benzilic), 5.04 (AB q, 2H, J = 12 Hz, OCH2 benzilic), 6.61 (dd, 1H, J = 2 Hz, 8 Hz, H aromatic), 6.70–6.76 (m, 2H, aromatic), 7.22–7.24 (m, 2H, aromatic), 7.29–7.32 (m, 3H, aromatic) 9.14 (s, 1H, NH).
Benzyl4-(2-chlorophenyl)-2,7,7-trimethyl-5-oxo-1,4,5,6,7,8-hexahydroquinoline-3-carboxylate (Table 5, Entry 18, Figures S14 and S15)
Solid, m.p.178–180 °C. 1H NMR (400 MHz, DMSO-d6): δ (ppm) 0.84(s, 3H, CH3), 1.00 (s, 3H, CH3), 1.91 (d, 1H, J = 16 Hz, CH2), 2.14 (d, 1H, J = 16 Hz, CH2), 2.28 (s, 3H, CH3), 2.25–2.240 (m, 2H, CH2), 4.99 (AB q, 2H, J = 12 Hz, OCH2 benzilic), 5.21 (s, 1H, benzilic), 7.08–7.27 (m, 9H, aromatic), 9.17 (s, 1H, NH), 13C-NMR (100 MHz, DMSO-d6): δ (ppm) 18.86, 21.70, 26.82, 29.61, 32.44, 35.49, 46.87, 50.69, 56.52, 56.03, 101.83, 103.14, 110.13, 127.72,128.09, 128.65, 129.56, 132.07, 132.56, 137.27, 145.47, 146.37, 150.12, 166.99, 172.64, 194.41.
Benzyl4-(3-hydroxyphenyl)-2,7,7-trimethyl-5-oxo-1,4,5,6,7,8-hexahydroquinoline-3-carboxylate (Table 5, Entry 19, Figures S16 and S17)
Solid, m.p.212–214 °C. 1H NMR (400 MHz, DMSO-d6): δ (ppm) 0.85 (s, 3H, CH3), 1.00 (s, 3H, CH3), 1.97 (d, 1H, J = 16 Hz, CH2), 2.13 (d, 1H, J = 16 Hz, CH2), 2.30 (s, 3H, CH3), 2.24–2.230 (m, 2H, CH2), 4.89 (s, 1H, benzilic), 5.04 (AB q, 2H, J = 12Hz, OCH2 benzilic), 6.48 (dd, 1H, J = 1.6 Hz, 8 Hz, aromatic), 7.56–6.61 (m, 2H, aromatic), 6.94 (t, 1H, J = 8 Hz, aromatic), 7.18–7.21 (m, 2H, aromatic), 7.28–7.31 (m, 4H, aromatic, OH), 9.11 (s, 1H, NH), 13C-NMR (100 MHz, DMSO-d6): δ (ppm) 18.91, 26.99, 29.57, 32.61, 35.96, 50.75, 56.51, 65.17, 103.45, 110.60, 113.16, 113.16, 115.02, 118.73, 128.01, 128.10, 128.76, 1129.03, 137.21, 146.18, 149.25, 149.74, 157.42, 167.17, 194.79.
Benzyl4-(2-hydroxy-3-methoxyphenyl)-2,7,7-trimethyl-5-oxo-1,4,5,6,7,8-hexahydroquinoline-3-carboxylate (Table 5, Entry 20, Figures S18 and S19)
Solid, m.p.248–250 °C. 1H NMR (400 MHz, DMSO-d6): δ (ppm) 0.78 (s, 3H, CH3), 1.01 (s, 3H, CH3), 2.09 (d, 1H, J = 16 Hz, CH2), 2.15 (d, 1H, J = 16 Hz, CH2), 2.41–2.45 (m, 5H, CH2, CH3), 3.70 (s, 3H, OCH3), 4.97 (AB q, 2H, J = 13.2 Hz, OCH2 benzilic), 5.08 (s, 1H, benzilic), 6.54 (dd, 1H, J = 1.6 Hz, 7.6 Hz, H aromatic), 6.65–6.73 (m, 2H, aromatic), 6.99–7.01 (m, 2H, aromatic), 7.19–7.23 (m, 3H, aromatic), 9.26 (s, 1H, OH), 9.43 (s, 1H, NH).
Benzyl4-(3-hydroxy-4-methoxyphenyl)-2,7,7-trimethyl-5-oxo-1,4,5,6,7,8-hexahydroquinoline-3-carboxylate (Table 5, Entry 22, Figure S20)
Solid, m.p.141–143 °C. 1H NMR (400 MHz, DMSO-d6): δ (ppm) 0.85 (s, 3H, CH3), 1.00 (s, 3H, CH3), 1.98 (d, 1H, J = 16 Hz, CH2), 2.24–2.41 (m, 6H, CH2, CH3), 3.68 (s, 3H, OCH3), 4.78 (s, 1H, benzilic), 5.03 (AB q, 2H, J = 13.6 Hz, OCH2 benzilic), 6.51(dd, 1H, J = 2 Hz, 8.4 Hz, H aromatic), 6.62–6.70 (m, 2H, aromatic), 7.19–7.21 (m, 2H, aromatic), 7.28–7.31 (m, 3H, aromatic), 8.68 (s, 1H, OH), 9.08 (s, 1H, NH), 13C-NMR (100 MHz, DMSO-d6): δ (ppm) 18.89, 27.03, 29.58, 32.60, 35.31, 50.78, 56.02, 65.13, 103.78, 110.83, 112.05, 115.61, 118.54, 128.01, 128.09, 128.75, 137.24, 140.86, 145.81, 146.18, 146.30, 149.45, 167.25, 194.83.
Dibenzyl4,4′-(1,4-phenylene)bis(2,7,7-trimethyl-5-oxo-1,4,5,6,7,8-hexahydroquinoline-3-carboxylate) (Table 5, Entry 23, Figures S21 and S22)
Solid, m.p.327–330 °C. 1H NMR (400 MHz, DMSO-d6): δ (ppm) 0.81(s, 3H, CH3), 0.98 (s, 3H, CH3), 1.98 (d, 1H, J = 16 Hz, CH2), 2.10–2.15 (m, 1H, J = 16 Hz, CH2), 2.30 (s, 3H, CH3), 2.29–2.236 (m, 2H, CH2), 4.84 (s, 1H, benzilic), 4.99 (AB q, 2H, J = 12 Hz, OCH2 benzilic), 6.89–6.90 (m, 2H, aromatic), 7.12–7.17 (m, 2H, aromatic), 7.26–7.28 (m, 3H, aromatic), 9.12 (s, 1H, NH), 13C-NMR (100 MHz, DMSO-d6): δ (ppm) 26.84, 27.36, 29.30, 29.57, 32.64, 35.26, 35.47, 45.81, 50.70, 65.20, 103.35, 103.49, 110.51, 110.68, 127.95, 128.12, 128.71, 137.10, 145.10, 145.30, 146.37, 149.79, 150.00, 167.16, 194.88.
Dibenzyl4,4′-((hexane-1,6-diylbis(oxy))bis(2,1-phenylene))bis(2,7,7-trimethyl-5-oxo-1,4,5,6,7,8-hexahydroquinoline-3-carboxylate) (Table 5, Entry24, Figures S23 and S24)
Solid, m.p.161–163 °C. 1H NMR (300 MHz, DMSO-d6): δ = 0.84 (s, 3H, CH3), 1.00 (s, 3H, CH3), 1.49 (br, 2H, CH2 bridge), 1.72 (br, 2H, CH2 bridge), 1.90 (d,1H, J = 16 Hz, CH2), 2.13–2.39 (m, 5H, J = 18 Hz, CH2, CH3), 2.48 (d, 1H, J = 16 Hz CH2), 3.82 (dd, 2H, J = 7.2, 38.4 Hz OCH2 bridge), 4.97 (AB q, 2H, J = 12 Hz, OCH2), 5.08 (s, 1H, benzlic), 6.68–6.84 (m, 2H, aromatic), 7.03–7.29 (m, 7H, aromatic), 9.02 (s, 1H, NH), 13C NMR(300 MHz, DMSO-d6): δ = 18.92, 26.13, 26.63, 29.71, 29.83, 32.40, 34.77, 50.87, 64.99, 67.93, 102.59, 109.29, 112.10, 119.57, 127.44, 128.04, 128.13, 128.66, 132.09, 134.71, 137.33, 145.50, 150.05, 157.57, 167.53, 194.37 ppm.
3. Experimental Section
3.1. Materials
Paraphenylenediamine (pPDA), ammonium persulfate (APS), pyridine, sulfuric acid, dimedone, Iron (II), and (III) slats, benzyl acetoacetate, ammonium acetate, DPPH (2,2-diphenyl-1-picrylhydrazyl) radical scavenging, and all employed solvents were provided by Merck company (Germany).
3.2. Preparation of Iron Oxide Nanoparticles
Iron oxide nanoparticles (Fe3O4 NPs) were prepared by the co-precipitation technique as follows [40]. FeCl3·6H2O (2.73 g) and FeCl2·4H2O (0.99 g) were dissolved in deionized water at ambient temperature, and then 10 mL ammonia solution (25%) was added into the above solution under constant stirring for a half-hour, and the final pH was 10. Lastly, the black precipitate was isolated by a magnet and washed with distilled water and ethanol, and dried at 80 ◦C under vacuum for 2 h.
3.3. Pyridinium Hydrogen Sulfate [HPy][HSO4] Preparation
Pyridinium hydrogen sulfate [HPy][HSO4] was prepared as follows (Scheme 2a) [41]. 10 mL of pyridine was poured into a flask, then 6.76 mL of sulfuric acid solution was added slowly into pyridine for one hour under stirring at 0–5 °C. Afterward, the solution was maintained for 5 h at 0–5 °C to complete the reaction. Lastly, water was removed by a rotary evaporator to give a colorless liquid.
Scheme 2.
Preparation of (a) [HPy][HSO4] and (b) PpPDA@Fe3O4 nanocomposite in the presence of [HPy][HSO4]. Note: The relative size of nanoparticles and chemical structures in the scheme is assumptive.
3.4. Fabrication of Poly(p-Phenylenediamine)@Fe3O4 in [HPy][HSO4] Ionic Liquid
The magnetic poly(p-phenylenediamine)@Fe3O4 (PpPDA@Fe3O4) was fabricated through the in-situ chemical oxidative polymerization in presence of iron oxide nanoparticles and [HPy][HSO4] ionic liquid as follows:
1 g of pPDA monomer was dissolved in the 30 mL of distilled water under constant stirring at room temperature and then 9.24 mmol of [HPy][HSO4] (optimized amount) was added to the solution. In a separate beaker, iron oxide nanoparticles (0.05 g) in 15 mL of distilled water were dispersed under ultrasonic irradiation for 30 min. Then, the iron oxide nanoparticles mixture was added to the above solution. The polymerization was initiated by the addition of 10 mL of the ammonium persulfate solution (0.99 mol/L) under constant stirring at room temperature. The mixture was retained under constant stirring at room temperature for 24 h. The precipitate was collected by the external magnet and washed with deionized water and methanol and dried at 70° for 24 h (Scheme 2b). For a better comparison of the catalytic activity of nanocomposite, PpPDAs in the presence and absence of [HPy][HSO4] were also synthesized according to the above procedure.
3.5. Overall Route for the Synthesis of Polyhydroquinoline Derivatives
One-pot synthesis of polyhydroquinoline compounds was carried out as follows:
A mixture of dimedone (1.0 mmol), aldehyde (1.0 mmol), benzyl acetoacetate (1.0 mmol), ammonium acetate (1.0 mmol), and PpPDA@Fe3O4 (0.04 g) in ethanol solvent (5 mL) was refluxed. Rection was traced by thin-layer chromatography (hexane/ethyl acetate 5:1). Once the reaction was completed the catalyst was separated easily by an external magnet. Afterward, the crude solid product was filtered and then purified by recrystallization from ethanol.
3.6. Antioxidant Activity
Antioxidant activity evaluation of prepared materials was studied in ethanolic DPPH solution (25 μM/L) by a UV-vis spectroscopy. The amount of each sample (10 mg) was added to tubes containing2 mL of ethanolic DPPH and then the tubes were kept in a dark place for 6 h. After that, DPPH inhibition (%) was measured by the following Equation:
DPPH inhibition (%) = (Ab − As)/Ab × 100
In this equation, Ab and As are the absorption of DPPH solution and samples at 517 nm, respectively.
3.7. Antibacterial Activity
Kirby–Bauer disc diffusion technique was employed for antibacterial activities study of the prepared samples. Sample solutions (20 mg in 10 mL dimethyl sulfoxide, DMSO) were filtered by a Ministart (Sartorius). The antibacterial activity of the samples was evaluated against Bacillus subtilis PTCC 1023 (Gram-positive) and Escherichia coli PTCC 1330 (Gram-negative) bacterial species. The bacteria phase was prepared via inoculating of the cultures 1% (v/v) into the Muller–Hinton broth and incubating on a shaker at 37 °C for 24 h. Sterile paper discs were soaked with 10 μL of the sample solutions then allowed to dry. The soaked discs were placed on the agar plate and incubated at 37 °C for 24 h. The antibacterial activities of the compounds were compared with gentamicin and chloramphenicol antibiotics as positive control and DMSO as a negative control. Antibacterial activity was studied by evaluating the inhibition zone diameter (mm) of the surface of the plates and the results were reported as Mean ± SD after three repeats.
3.8. Characterization
The chemical structure of the synthesized materials was investigated by a Fourier transform infrared spectroscopy (FTIR) (Bruker Tensor 27, Bremen, Germany), hydrogen and carbon nuclear magnetic resonance spectroscopy (1HNMR and 13CNMR) (Bruker Avance DRX-400, Bremen, Germany), elemental analysis (CHNS) (Costech-Italy) and energy dispersive X-ray (EDX) (MIRA 3-XMU, Brno, Czech Republic). The surface morphology and crystallinity of products were evaluated by field emission scanning electron microscopy (FESEM) (MIRA 3-XMU, Czech Republic) and X-ray diffraction (XRD) (BrukerD8 Advance X-ray diffractometer, Bremen, Germany), respectively.
4. Conclusions
Antibacterial and antioxidant PpPDA@Fe3O4 nanocomposite was successfully fabricated by in-situ oxidative polymerization in the presence of [HPy][HSO4] and iron oxide nanoparticles as a potential heterogeneous nanocatalyst for the synthesis of polyhydroquinolines derivatives. The nanocatalyst was characterized by different techniques and results displayed that the nanocatalyst showed superparamagnetic behavior with crystalline nature. The solubility test showed that prepared PpPDA in presence of [HPy][HSO4] had better solubility than PpPDA. The PpPDA@Fe3O4 nanocatalyst showed good antibacterial activity against Escherichia coli and Bacillus subtilis. The FESEM of nanocatalyst showed the hexagonal structure with a high agglomerate with a diameter of ~100 nm. The PpPDA@Fe3O4 nanocatalyst showed great catalytic performance in the synthesis of polyhydroquinolines derivatives and the corresponding products were synthesized with high yield (90–97%) without a difficult work-up procedure. Moreover, the PpPDA@Fe3O4 nanocatalyst separated easily from the reaction media by a magnet. Reusability results showed that the nanocatalyst could use for at least five times without a significant decrease in catalytic activity. According to the proposed mechanistic scheme, the prepared PpPDA@Fe3O4 nanocatalyst in [HPy][HSO4] played an important role in directing the synthesis reaction of polyhydroquinolines derivatives with favorable features, e.g., Brønsted acid, strong basic sites, and high surface area. It could be concluded the bioactive PpPDA@Fe3O4 nanocomposite could be employed as an eco-friendly and high efficiency nanocatalyst for the synthesis of different organic reactions. PpPDA@Fe3O4 nanocatalysts and 11 polyhydroquinolines derivatives showed antioxidant activity between 75% and 99%. Among polyhydroquinolines derivatives, only 5r and 5v had good growth inhibitory effects against tested microorganisms.
Supplementary Materials
The following supporting information can be downloaded. Figure S1: 1H-NMR spectra of benzyl 2,7,7-trimethyl-4-(4-nitrophenyl)-5-oxo-1,4,5,6,7,8-hexahydroquinoline-3-carboxylate (Table 5, Entry2), Figure S2: 13C-NMR spectra of benzyl 2,7,7-trimethyl-4-(4-nitrophenyl)-5-oxo-1,4,5,6,7,8-hexahydroquinoline-3-carboxylate (Table 5, Entry2), Figure S3: 1H-NMR spectra of Benzyl¬4-(3-ethoxy-4-hydroxyphenyl)-2,7,7-trimethyl-5-oxo-1,4,5,6,7,8-hexahy¬droquino line -3-carboxylate (Table 5, Entry 3), Figure S4: 13C-NMR spectra of Benzyl¬4-(3-ethoxy-4-hydroxyphenyl)-2,7,7-trimethyl-5-oxo-1,4,5,6,7,8-hexahy¬droquino line -3-carboxylate (Table 5, Entry 3), Figure S5: 1H-NMR spectra of benzyl 2,7,7-trimethyl-5-oxo-4-(3,4,5-trimethoxyphenyl)-1,4,5,6,7,8-hexahydroquinoline-3-carboxylate (Table 5, Entry 5), Figure S6: 13C-NMR spectra of benzyl 2,7,7-trimethyl-5-oxo-4-(3,4,5-trimethoxyphenyl)-1,4,5,6,7,8-hexahydroquinoline-3-carboxylate (Table 5, Entry 5), Figure S7: 1H-NMR spectra of Benzyl¬2,7,7-trimethyl-5-oxo-4-(p-tolyl)-1,4,5,6,7,8-hexahydroquinoline-3-carboxylate (Table 5, Entry 9), Figure S8: 13C-NMR spectra of Benzyl¬2,7,7-trimethyl-5-oxo-4-(p-tolyl)-1,4,5,6,7,8-hexahydroquinoline-3-carboxylate (Table 5, Entry 9), Figure S9: 1H-NMR spectra of Benzyl 2,7,7-trimethyl-4-(4-(methylthio)phenyl)-5-oxo-1,4,5,6,7,8-hexahydroquinoline-3-carboxylate (Table 5, Entry10), Figure S10: 13C-NMR spectra of Benzyl 2,7,7-trimethyl-4-(4-(methylthio)phenyl)-5-oxo-1,4,5,6,7,8-hexahydroquinoline-3-carboxylate (Table 5, Entry10), Figure S11: 1H-NMR spectra of benzyl 4-(4-ethylphenyl)-2,7,7-trimethyl-5-oxo-1,4,5,6,7,8-hexahydroquinoline-3-carboxylate(Table 5, Entry 13), Figure S12: 13C-NMR spectra of benzyl 4-(4-ethylphenyl)-2,7,7-trimethyl-5-oxo-1,4,5,6,7,8-hexahydroquinoline-3-carboxylate(Table 5, Entry 13), Figure S13: 1H-NMR spectra of Benzyl 4-(3,4-dimethoxyphenyl)-2,7,7-trimethyl-5-oxo-1,4,5,6,7,8-hexahydroquinoline-3-carboxylate (Table 5, Entry15), Figure S14: 1H-NMR spectra of benzyl 4-(2-chlorophenyl)-2,7,7-trimethyl-5-oxo-1,4,5,6,7,8-hexahydroquinoline-3-carboxylate (Table 5, Entry 18), Figure S15: 13C-NMR spectra of benzyl 4-(2-chlorophenyl)-2,7,7-trimethyl-5-oxo-1,4,5,6,7,8-hexahydroquinoline-3-carboxylate (Table 5, Entry 18), Figure S16: 1H-NMR spectra of benzyl 4-(3-hydroxyphenyl)-2,7,7-trimethyl-5-oxo-1,4,5,6,7,8-hexahydroquinoline-3-carboxylate (Table 5, Entry 19), Figure S17: 13C-NMR spectra of benzyl 4-(3-hydroxyphenyl)-2,7,7-trimethyl-5-oxo-1,4,5,6,7,8-hexahydroquinoline-3-carboxylate (Table 5, Entry 19), Figure S18: 1H-NMR spectra of benzyl 4-(2-hydroxy-3-methoxyphenyl)-2,7,7-trimethyl-5-oxo-1,4,5,6,7,8-hexahydroquinoline-3-carboxylate (Table 5, Entry 20), Figure S19: 13C-NMR spectra of benzyl 4-(3-hydroxy-4-methoxyphenyl)-2,7,7-trimethyl-5-oxo-1,4,5,6,7,8-hexahydroquinoline-3-carboxylate (Table 5, Entry 20), Figure S20: 1H-NMR spectra of benzyl 4-(3-hydroxy-4-methoxyphenyl)-2,7,7-trimethyl-5-oxo-1,4,5,6,7,8-hexahydroquinoline-3-carboxylate(Table 5, Entry22), Figure S21: 1H-NMR spectra of dibenzyl 4,4′-(1,4-phenylene)bis(2,7,7-trimethyl-5-oxo-1,4,5,6,7,8-hexahydroquinoline-3-carboxylate) (Table 5, Entry23), Figure S22: 13C-NMR spectra of dibenzyl 4,4′-(1,4-phenylene)bis(2,7,7-trimethyl-5-oxo-1,4,5,6,7,8-hexahydroquinoline-3-carboxylate) (Table 5, Entry 23), Figure S23: 1H-NMR spectra of Dibenzyl 4,4′-((hexane-1,6-diylbis(oxy))bis(2,1-phenylene))bis(2,7,7-trimethyl-5-oxo-1,4,5,6,7,8-hexahydroquinoline-3-carboxylate) (Table 5, Entry24), Figure S24: 13C-NMR Spectra of dibenzyl 4,4′-((hexane-1,6-diylbis(oxy))bis(2,1-phenylene))bis(2,7,7-trimethyl-5-oxo-1,4,5,6,7,8-hexahydroquinoline-3-carboxylate) (Table 5, Entry24).
Author Contributions
Methodology, S.M.N. and A.D.; investigation, S.M.N.; writing—original draft preparation, E.N.Z.; writing—review and editing, E.N.Z., S.A.P., M.A. and A.P.K.; supervision, E.N.Z.; project administration, E.N.Z. and S.A.P. All authors have read and agreed to the published version of the manuscript.
Funding
APK was supported by a grant from the Singapore Ministry of Education (MOE-T2EP30120-0016) as well as the National Research Foundation Singapore and the Singapore Ministry of Education under its Research Center of Excellence initiative to the Cancer Science Institute of Singapore, and the National University of Singapore.
Acknowledgments
E.N.Z. and S.A.P. are thankful to Damghan University for the financial support of current research.
Conflicts of Interest
The authors declare no conflict of interest.
References
- Xu, P.; Liang, S.; Zong, M.-H.; Lou, W.-Y. Ionic liquids for regulating biocatalytic process: Achievements and perspectives. Biotechnol. Adv. 2021, 51, 107702. [Google Scholar] [CrossRef] [PubMed]
- Cull, S.G.; Holbrey, J.D.; Vargas-Mora, V.; Seddon, K.R.; Lye, G.J. Room-temperature ionic liquids as replacements for organic solvents in multiphase bioprocess operations. Biotechnol. Bioeng. 2000, 69, 227–233. [Google Scholar] [CrossRef]
- Erbeldinger, M.; Mesiano, A.J.; Russell, A.J. Enzymatic catalysis of formation of Z-aspartame in ionic liquid−an alternative to enzymatic catalysis in organic solvents. Biotechnol. Prog. 2000, 16, 1129–1131. [Google Scholar] [CrossRef] [PubMed]
- Egorova, K.S.; Posvyatenko, A.V.; Larin, S.S.; Ananikov, V.P. Ionic liquids: Prospects for nucleic acid handling and delivery. Nucleic Acids Res. 2021, 49, 1201–1234. [Google Scholar] [CrossRef] [PubMed]
- Egorova, K.S.; Gordeev, E.G.; Ananikov, V.P. Biological Activity of Ionic Liquids and Their Application in Pharmaceutics and Medicine. Chem. Rev. 2017, 117, 7132–7189. [Google Scholar] [CrossRef]
- Abbott, A.P.; McKenzie, K.J. Application of ionic liquids to the electrodeposition of metals. Phys. Chem. Chem. Phys. 2006, 8, 4265–4279. [Google Scholar] [CrossRef] [PubMed]
- Hallett, J.P.; Welton, T. Room-temperature ionic liquids: Solvents for synthesis and catalysis. 2. Chem. Rev. 2011, 111, 3508–3576. [Google Scholar] [CrossRef]
- Pahovnik, D.; Žagar, E.; Kogej, K.; Vohlídal, J.; Žigon, M. Polyaniline nanostructures prepared in acidic aqueous solutions of ionic liquids acting as soft templates. Eur. Polym. J. 2013, 49, 1381–1390. [Google Scholar] [CrossRef]
- Harun, M.H.; Saion, E.; Kassim, A.; Yahya, N.; Mahmud, E. Conjugated Conducting Polymers: A Brief Overview. Sens. Peterbrgh. NH 2007, 2, 63–68. [Google Scholar]
- Zare, E.N.; Agarwal, T.; Zarepour, A.; Pinelli, F.; Zarrabi, A.; Rossi, F.; Ashrafizadeh, M.; Maleki, A.; Shahbazi, M.-A.; Maiti, T.K. Electroconductive multi-functional polypyrrole composites for biomedical applications. Appl. Mater. Today 2021, 24, 101117. [Google Scholar] [CrossRef]
- Zare, E.N.; Lakouraj, M.M.; Ashna, A. Synthesis of conductive poly (3-aminobenzoic acid) nanostructures with different shapes in acidic ionic liquids medium. J. Mol. Liq. 2018, 271, 514–521. [Google Scholar] [CrossRef]
- Zare, E.N.; Motahari, A.; Sillanpää, M. Nanoadsorbents based on conducting polymer nanocomposites with main focus on polyaniline and its derivatives for removal of heavy metal ions/dyes: A review. Environ. Res. 2018, 162, 173–195. [Google Scholar] [CrossRef] [PubMed]
- Donescu, D.; Fierascu, R.C.; Ghiurea, M.; Manaila-Maximean, D.; Nicolae, C.A.; Somoghi, R.; Spataru, C.I.; Stanica, N.; Raditoiu, V.; Vasile, E. Synthesis and magnetic properties of inverted core-shell polyaniline-ferrite composite. Appl. Surf. Sci. 2017, 414, 8–17. [Google Scholar] [CrossRef]
- Zare, E.N.; Makvandi, P.; Ashtari, B.; Rossi, F.; Motahari, A.; Perale, G. Progress in Conductive Polyaniline-Based Nanocomposites for Biomedical Applications: A Review. J. Med. Chem. 2020, 63, 1–22. [Google Scholar] [CrossRef]
- Livi, S.; Gérard, J.F.; Duchet-Rumeau, J. Ionic liquids as polymer additives. In Applications of Ionic Liquids in Polymer Science and Technology; Mecerreyes, D., Ed.; Springer: Berlin/Heidelberg, Germany, 2015; pp. 1–21. ISBN 9783662449035. [Google Scholar]
- Krishna, A.; Laslau, C.; Waterhouse, G.I.N.; Zujovic, Z.D.; Travas-Sejdic, J. Effect of ionic liquid on polyaniline chemically synthesised under falling-pH conditions. Chem. Pap. 2013, 67, 995–1001. [Google Scholar] [CrossRef]
- Miao, Z.; Wang, Y.; Liu, Z.; Huang, J.; Han, B.; Sun, Z.; Du, J. Synthesis of polyaniline nanofibrous networks with the aid of an amphiphilic ionic liquid. J. Nanosci. Nanotechnol. 2006, 6, 227–230. [Google Scholar] [CrossRef]
- Arias, L.S.; Pessan, J.P.; Vieira, A.P.M.; De Lima, T.M.T.; Delbem, A.C.B.; Monteiro, D.R. Iron oxide nanoparticles for biomedical applications: A perspective on synthesis, drugs, antimicrobial activity, and toxicity. Antibiotics 2018, 7, 46. [Google Scholar] [CrossRef] [Green Version]
- Bahadorikhalili, S.; Ma’mani, L.; Mahdavi, H.; Shafiee, A. Palladium catalyst supported on PEGylated imidazolium based phosphinite ionic liquid-modified magnetic silica core–shell nanoparticles: A worthy and highly water-dispersible catalyst for organic reactions in water. RSC Adv. 2015, 5, 71297–71305. [Google Scholar] [CrossRef]
- Eivazzadeh-Keihan, R.; Maleki, A. Design and synthesis of a new magnetic aromatic organo-silane star polymer with unique nanoplate morphology and hyperthermia application. J. Nanostructure Chem. 2021, 11, 751–767. [Google Scholar] [CrossRef]
- Marzouk, A.A.; Abu-Dief, A.M.; Abdelhamid, A.A. Hydrothermal preparation and characterization of ZnFe2O4 magnetic nanoparticles as an efficient heterogeneous catalyst for the synthesis of multi-substituted imidazoles and study of their anti-inflammatory activity. Appl. Organomet. Chem. 2018, 32, e3794. [Google Scholar] [CrossRef]
- Babudurai, M.; Nwakanma, O.; Romero-Nuñez, A.; Manisekaran, R.; Subramaniam, V.; Castaneda, H.; Jantrania, A. Mechanical activation of TiO2/Fe2O3 nanocomposite for arsenic adsorption: Effect of ball-to-powder ratio and milling time. J. Nanostructure Chem. 2021, 11, 619–632. [Google Scholar] [CrossRef]
- Halim, E.M.; Perrot, H.; Sel, O.; Debiemme-Chouvy, C.; Lafdi, K.; El Rhazi, M. Electrosynthesis of hierarchical Cu2O–Cu(OH)2 nanodendrites supported on carbon nanofibers/poly(para-phenylenediamine) nanocomposite as high-efficiency catalysts for methanol electrooxidation. Int. J. Hydrog. Energy 2021, 46, 19926–19938. [Google Scholar] [CrossRef]
- Su, X.; Yao, Y.; Tian, J.; Liu, J.; Wang, Z.; You, Y.; Huang, L.; Wu, C. Investigation of the durability of a poly-p-phenylenediamine/carbon black composite for the oxygen reduction reaction. Chin. J. Catal. 2016, 37, 1096–1102. [Google Scholar] [CrossRef]
- Mirzaei-Mosbat, M.; Ghorbani-Vaghei, R.; Karamshahi, Z. Layered double hydroxides@poly(p-phenylenediamine)@Cu as a novel catalyst for the synthesis of pyrrole derivatives: Preparation and characterization. Res. Chem. Intermed. 2020, 46, 1613–1628. [Google Scholar] [CrossRef]
- Karamshahi, Z.; Ghorbani-Vaghei, R. Facile synthesis of indolizines using layered double hydroxides@poly(p-phenylenediamine) as a catalyst with a green tool (neat technology). Appl. Organomet. Chem. 2020, 34, e5347. [Google Scholar] [CrossRef]
- Ortiz, M.E.; Núñez-Vergara, L.J.; Camargo, C.; Squella, J.A. Oxidation of Hantzsch 1, 4-dihydropyridines of pharmacological significance by electrogenerated superoxide. Pharm. Res. 2004, 21, 428–435. [Google Scholar] [CrossRef]
- Bossert, F.; Meyer, H.; Wehinger, E. 4-Aryldihydropyridines, a New Class of Highly Active Calcium Antagonists. Angew. Chem. Int. Ed. 1981, 20, 762–769. [Google Scholar] [CrossRef]
- Kazemi, M.; Mohammadi, M. Magnetically Recoverable Catalysts: Catalysis in Synthesis of Polyhydroquinolines. Appl. Organomet. Chem. 2020, 34, 42–48. [Google Scholar] [CrossRef]
- Ahankar, H.; Ramazani, A.; Joo, S.W. Magnetic nickel ferrite nanoparticles as an efficient catalyst for the preparation of polyhydroquinoline derivatives under microwave irradiation in solvent-free conditions. Res. Chem. Intermed. 2016, 42, 2487–2500. [Google Scholar] [CrossRef]
- Balaji, G.L.; Rajesh, K.; Venkatesh, M.; Sarveswari, S.; Vijayakumar, V. Ultrasound-promoted synthesis of bi-, tri- and tetrapodal polyhydroquinolines, 1,4-dihydropyridines and the corresponding pyridines. RSC Adv. 2014, 4, 39–46. [Google Scholar] [CrossRef]
- Amer, I.; Brandt, S. Synthesis and characterization of Poly(p-phenylenediamine) and its derivatives using aluminium triflate as a co-catalyst. Cogent Eng. 2018, 5, 1499701. [Google Scholar] [CrossRef]
- Arya, V.; Philip, L. Adsorption of pharmaceuticals in water using Fe3O4 coated polymer clay composite. Microporous Mesoporous Mater. 2016, 232, 273–280. [Google Scholar] [CrossRef]
- Muhammad, A.; Bilal, S. Comparative study of the adsorption of Acid Blue 40 on polyaniline, magnetic oxide and their composites: Synthesis, characterization and application. Materials 2019, 12, 2854. [Google Scholar] [CrossRef] [PubMed] [Green Version]
- Loh, K.-S.; Lee, Y.H.; Musa, A.; Salmah, A.A.; Zamri, I. Use of Fe3O4 nanoparticles for enhancement of biosensor response to the herbicide 2, 4-dichlorophenoxyacetic acid. Sensors 2008, 8, 5775–5791. [Google Scholar] [CrossRef] [PubMed]
- Davarpanah, A.; Zare, E.N.; Zamani, M. Acidic ionic liquid-mediated preparation of shaped electrically conductive poly (p-phenylenediamine). J. Polym. Res. 2021, 28, 224. [Google Scholar] [CrossRef]
- Mathew, J.; Sathishkumar, M.; Kothurkar, N.K.; Senthilkumar, R.; Narayanan, B.S. Polyaniline/Fe3O4-RGO nanocomposites for microwave absorption. In IOP Conference Series: Materials Science and Engineering; IOP Publishing: Bristol, UK, 2018; Volume 310, p. 12138. [Google Scholar]
- Kechrakos, D.; Trohidou, K.N. Magnetic properties of dipolar interacting single-domain particles. Phys. Rev. B 1998, 58, 12169. [Google Scholar] [CrossRef] [Green Version]
- Behbahani, F.K.; Homafar, M. Synthesis of polyhydroquinoline derivatives through the hantzsch four component using iron (III) phosphate as a catalyst. Synth. React. Inorg. Met. Nano-Metal Chem. 2012, 42, 291–295. [Google Scholar] [CrossRef]
- Wu, S.; Sun, A.; Zhai, F.; Wang, J.; Xu, W.; Zhang, Q.; Volinsky, A.A. Fe3O4 magnetic nanoparticles synthesis from tailings by ultrasonic chemical co-precipitation. Mater. Lett. 2011, 65, 1882–1884. [Google Scholar] [CrossRef]
- Tao, D.J.; Wu, Y.T.; Zhou, Z.; Geng, J.; Hu, X.B.; Zhang, Z.B. Kinetics for the esterification reaction of n -butanol with acetic acid catalyzed by noncorrosive brønsted acidic ionic liquids. Ind. Eng. Chem. Res. 2011, 50, 1989–1996. [Google Scholar] [CrossRef]
Publisher’s Note: MDPI stays neutral with regard to jurisdictional claims in published maps and institutional affiliations. |
© 2022 by the authors. Licensee MDPI, Basel, Switzerland. This article is an open access article distributed under the terms and conditions of the Creative Commons Attribution (CC BY) license (https://creativecommons.org/licenses/by/4.0/).